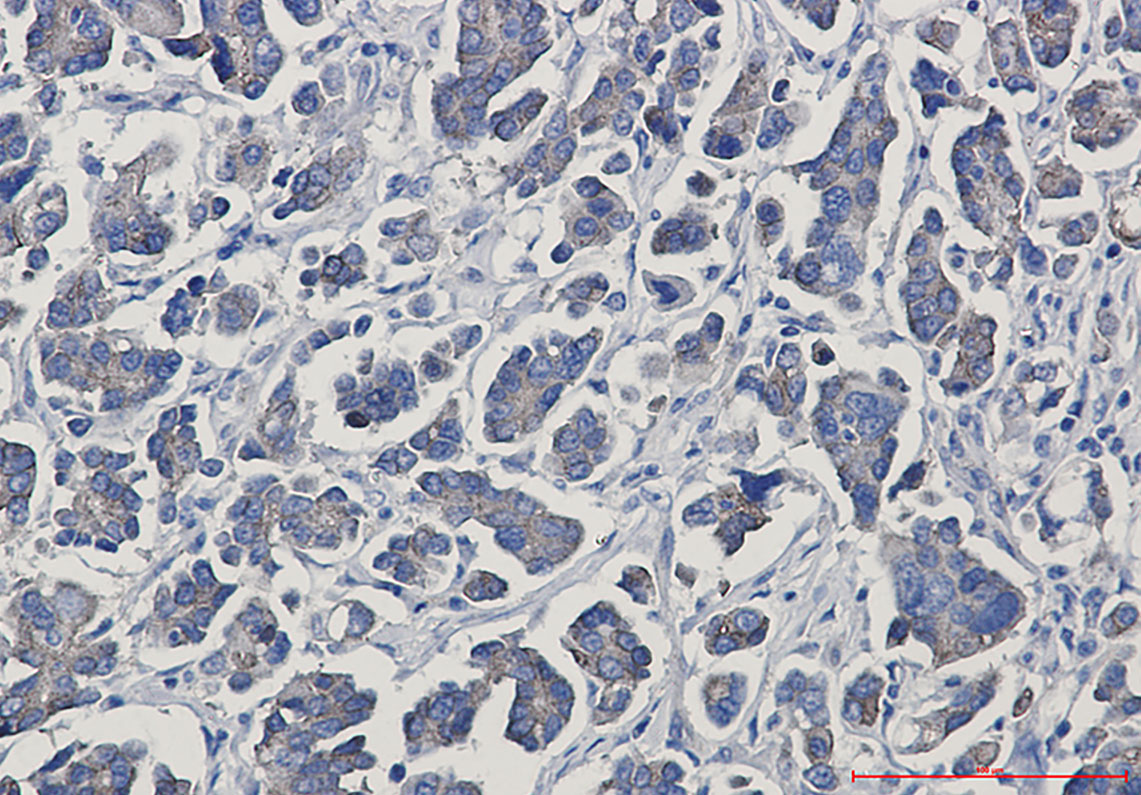

-
分类: 科研抗体货号: P22372别名: JUP; CTNNG; DP3; Junction plakoglobin; Catenin gamma; Desmoplakin III; Desmoplakin-3应用: WB,IHC,IF反应种属: Human
-
分类: 科研抗体货号: P22350别名: EPHB4; HTK; MYK1; TYRO11; Ephrin type-B receptor 4; Hepatoma transmembrane kinase; Tyrosine-protein kinase TYRO11应用: WB,IHC反应种属: Human,Mouse,Rat
-
分类: 科研抗体货号: P22332别名: DAGK; DAGK1; DGK-alpha应用: WB,IP,IHC反应种属: Human
-
分类: 科研抗体货号: P22371别名: Gal-1-P uridylyltransferase; UDP-glucose--hexose-1-phosphate uridylyltransferase应用: WB,IP反应种属: Human,Mouse,Rat
-
分类: 科研抗体货号: P22349别名: EPHB1; ELK; EPHT2; HEK6; NET; Ephrin type-B receptor 1; ELK; EPH tyrosine kinase 2; EPH-like kinase 6; EK6; hEK6; Neuronally-expressed EPH-related tyrosine kinase; NET; Tyrosine-protein kinase receptor EPH-2; EPHB2; DRT; EPHT3; EPTH3; ERK应用: WB,IP反应种属: Human
-
分类: 科研抗体货号: P22331别名: DENN; IG20; RAB3GEP应用: WB,IHC,IF反应种属: Human
-
分类: 科研抗体货号: P22369别名: FXR1; FXR1P; hFXR1p应用: WB,IHC,IF反应种属: Human,Mouse,Rat
-
分类: 科研抗体货号: P22348别名: Enactin; Ent; Entactin 1; Entactin; NID 1; NID; Nid1; Nidogen 1; Nidogen应用: WB,IHC反应种属: Human
-
分类: 科研抗体货号: P22358别名: EZR; VIL2; Ezrin; Cytovillin; Villin-2; p81应用: WB,IP,IHC反应种属: Human,Mouse,Rat
-
分类: 科研抗体货号: P22367别名: FKBP36应用: WB,IHC反应种属: Human,Mouse,Rat

鄂公网安备42018502007531号
鄂公网安备42018502007531号

